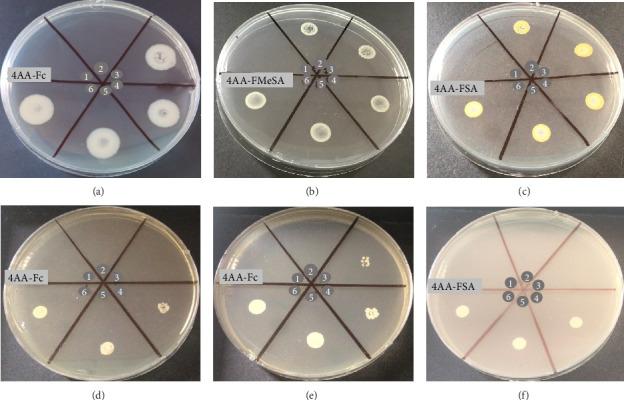
https://cdn.ncbi.nlm.nih.gov/pmc/blobs/89b4/11978478/ddb1455aa9bf/BCA2025-2786064.006.jpg

源自4-氨基安替比林的席夫碱:其计算机模拟、抗菌和抗癌作用及其在葡萄糖生物传感器设计中的应用研究
Schiff Bases From 4-Aminoantipyrine: Investigation of Their In Silico, Antimicrobial, and Anticancer Effects and Their Use in Glucose Biosensor Design.
作者信息
Erbaş Aşkın, Dikim Selinsu, Arslan Fatma, Bodur Onur Can, Arslan Seza, Özdemir Fatma, Sarı Nurşen
机构信息
Graduate School of Natural and Applied Sciences, Gazi University, Ankara, Türkiye.
Department of Chemistry, Faculty of Arts and Science, Kutahya Dumlupinar University, Kutahya, Türkiye.
出版信息
Bioinorg Chem Appl. 2025 Apr 1;2025:2786064. doi: 10.1155/bca/2786064. eCollection 2025.
Five new Schiff bases from 4-aminoantipyrine were synthesized, characterized, and evaluated for their antimicrobial and DNA cleavage activities, and drug similarity properties and cytotoxicity prediction using in silico analysis. All Schiff bases had good antibacterial and antifungal activities. All compounds showed self-activating DNA cleavage ability in the absence of any reductant or oxidant at low concentrations. Modified carbon paste electrodes were prepared with all Schiff bases, and a glucose biosensor was designed. Schiff base coded (4AA-Fc) was found to have the best sensitivity to HO. It was observed that the prepared biosensor has a working range at low concentrations (1.0 × 10-1.0 × 10 M ( = 1.0)) and a low detection limit (1.0 × 10 M). At the same time, 4AA-Fc was found to be a potent compound for bactericidal and fungicidal effect, killing pathogens. Thus, it could be used for the development of a resistant biosensor in external environment. It also showed a complete DNA degradation. In silico ADME analysis and cell line cytotoxicity studies found these new Schiff bases to have favorable drug-like properties, indicating potential for the development of therapeutic drugs. In particular, the compounds were not a P-gp substrate. Thus, they could be a potential anticancer agent. The present study may be useful for further scientific research in the field of the design, synthesis, and biological studies of bioactive substances.
合成、表征并评估了五种由4-氨基安替比林衍生的新型席夫碱,通过计算机模拟分析研究了它们的抗菌和DNA裂解活性、药物相似性性质以及细胞毒性预测。所有席夫碱均具有良好的抗菌和抗真菌活性。所有化合物在低浓度且无任何还原剂或氧化剂的情况下均表现出自激活DNA裂解能力。用所有席夫碱制备了修饰碳糊电极,并设计了一种葡萄糖生物传感器。发现编码为(4AA-Fc)的席夫碱对过氧化氢具有最佳的敏感性。观察到所制备的生物传感器在低浓度(1.0×10⁻¹.0×10⁻⁶M(n = 1.0))下具有工作范围和低检测限(1.0×10⁻⁷M)。同时,发现4AA-Fc是一种具有杀菌和杀真菌作用的有效化合物,能杀死病原体。因此,它可用于开发对外界环境有抗性的生物传感器。它还显示出完全的DNA降解。计算机模拟的ADME分析和细胞系细胞毒性研究发现这些新型席夫碱具有良好的类药物性质,表明具有开发治疗药物的潜力。特别是,这些化合物不是P-糖蛋白底物。因此,它们可能是潜在的抗癌剂。本研究可能有助于生物活性物质的设计、合成和生物学研究领域的进一步科学研究。